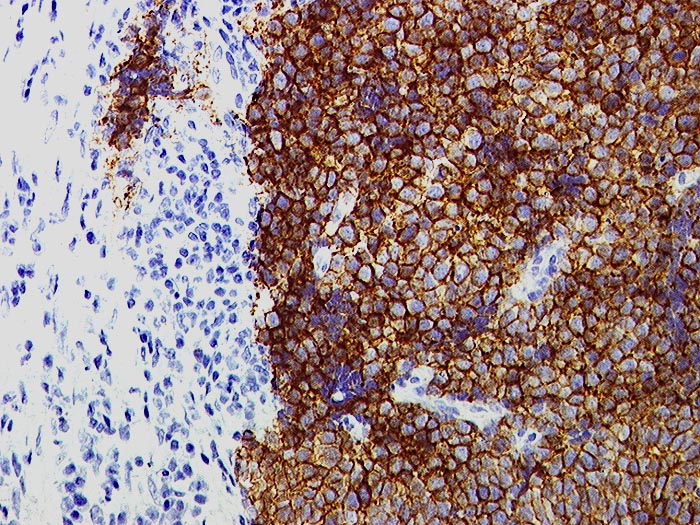

PathoPic – image database / PathoPic ID 1100 - Metastase kleinzelliges Karzinom
de
Diagnose
Metastase kleinzelliges Karzinom
Diagnose Gruppe
maligner Tumor
Topographie
Lymphknoten, mediastinal
Topographie Gruppe
Lymphatische Gewebe, KM, Milz
Beschreibung
Der schmale Zytoplasmasaum der Tumorzellen färbt sich stark positiv an. Links Reste des Lymphknotens.
Klinik
Vergrösserte Lymphknoten supraklavikulär rechts, thorakal und mediastinal. Unbekannter Primärtumor.
Bilder Typ
Histologie
Immunhistochemie
CD56
Alter
58
Geschlecht
unbekannt
Datum
Ersteintrag: 28.11.2001
Update: 04.02.2024